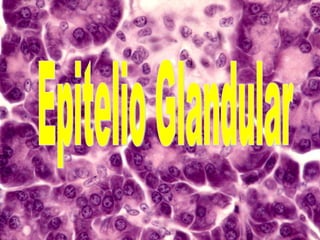
Epitelio Glandular

Este documento describe los tejidos básicos, con un enfoque en el tejido epitelial. Explica que el tejido epitelial está compuesto de células unidas firmemente que forman capas y cubren superficies. Se clasifica el tejido epitelial en membranas epiteliales y glándulas. Las membranas epiteliales se clasifican en simples (plano, cúbico, cilíndrico y seudoestratificado) y estratificadas (plano, cúbico y cilíndrico). C